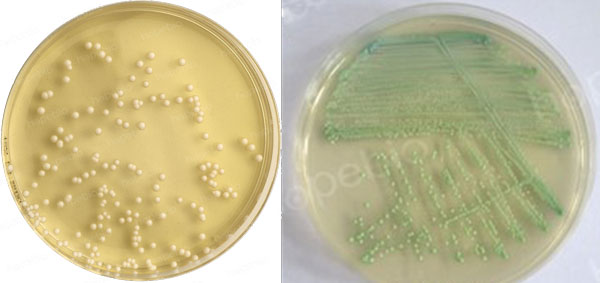

海博微信公众号
海博微信公众号
 海博天猫旗舰店
海博天猫旗舰店


 海博微信公众号
海博微信公众号
 海博天猫旗舰店
海博天猫旗舰店




一、白色念珠菌简介
白色念珠菌(Candida albicans)又叫白色假丝酵母,是一种双相真菌,在培养基上生长通常呈现酵母相,菌落呈白色圆形凸起,具有酵母的香味,显微镜下观察时菌体呈卵圆形,与一般的酵母菌无异,感染人体致病时一般呈现为菌丝相,菌体有细长菌丝芽管产生,可供菌体吸收营养和附着在人体组织表面。
二、活化方法
培养基的选择:白色念珠菌营养要求不高,通常使用沙氏葡萄糖琼脂/液体培养基或马铃薯葡萄糖琼脂培养基进行活化,在营养琼脂、TSA等细菌培养基上虽然也能生长,但较为缓慢,一般不常用。白色念珠菌在25-37℃培养均可生长,一般培养2-3天即可。
操作方法:若菌种为冻干粉形式,按照说明书溶解后,可直接涂布或划线至SDA/PDA平板上,也可加入至SDB/PDB等液体培养基中;若菌种为甘油冻存管形式,从冰箱中取出速融后,涂布或划线至SDA/PDA平板上,也可加入至SDB/PDB等液体培养基中;若菌种为瓷珠形式,挑取瓷珠可转入SDA/PDA平板上,也可加入至SDB/PDB等液体培养基中,20-25℃培养2-3天。
三、实验室常用保存方法
1.斜面保存法
将SDA或PDA培养基制成斜面管,接种白色念珠菌后培养至菌落生长良好,置于2-8℃可保存1-3个月,超过3个月容易出现菌种老化、污染、变异等现象,建议及时传代。
2.脱脂牛奶/甘油/瓷珠冷冻保存法
可挑取非选择性培养基上培养好的白色念珠菌至脱脂牛奶/液体/瓷珠菌种保存管中制成约108-109CFU/mL的菌液(瓷珠保存法需摇匀后弃菌液保留瓷珠),置于冰箱或液氮罐中冷冻保存,在-70℃以下可保存两年以上,在-20℃也能很容易保存一年以上,白色念珠菌生命力强,很容易保存数年或数十年。
四、菌种的确认
1.菌落特征:白色念珠菌在平板上菌落呈现白色圆形凸起状,具有酵母香味,在念珠菌显色平板上呈绿色菌落。
|
|
|
SDA平板 |
念珠菌显色平板 |
3.芽管试验:将白色念珠菌接种至吐温80-玉米粉琼脂上,20-25℃培养2-3天,挑取1环菌接种至兔血清,37℃培养2-3小时,镜检观察,菌体可产生芽管。
注:本文属海博生物原创,未经允许不得转载。



